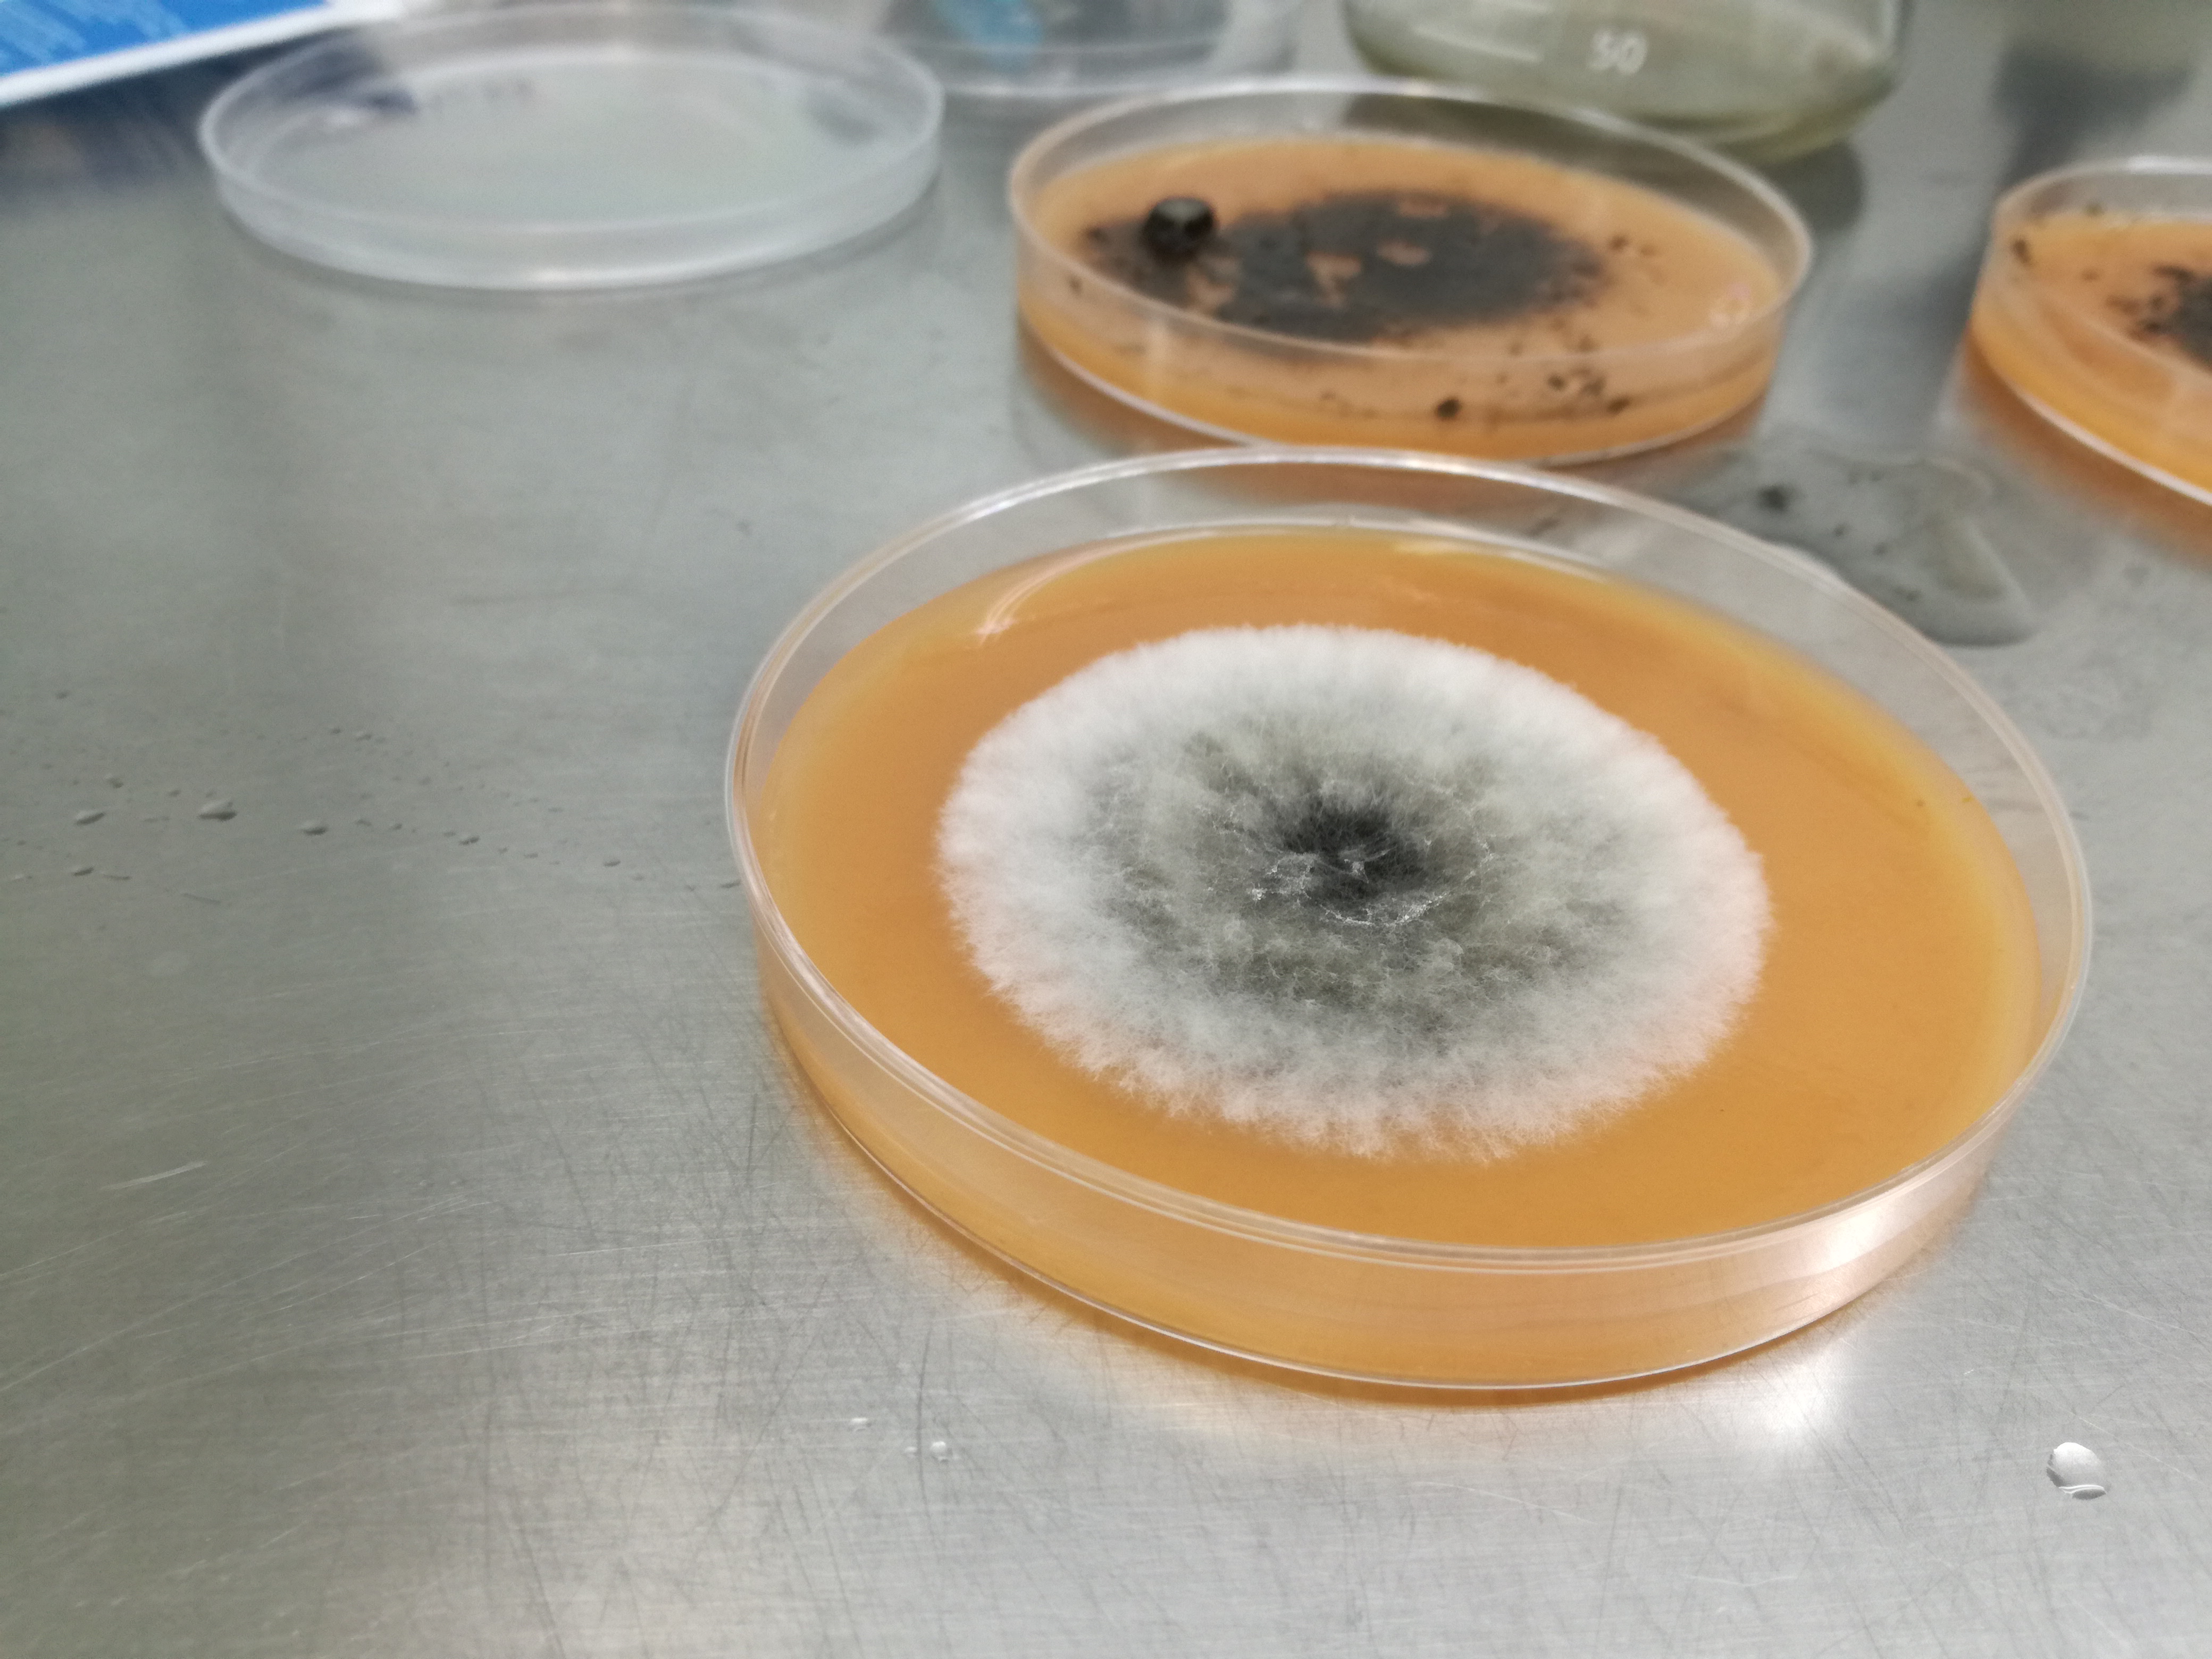

La estudiante de microbiología Dayanna Isabel Araque Gelves de décimo Semestre de la Universidad de Pamplona realizó estancia de investigación a través del programa DELFIN en la Ciudad Obregon, México, en el Instituto Tecnológico de Sonora ( ITSON), en el Laboratorio de Biotecnología Vegetal, en el área de interacción planta microorganismo, bajo la tutoria del Dr, Sergio de los Santos Villalobos, en donde desarrolló el proyecto "Evaluación de Bacillus subtilis para contrarrestar la infección provocada por Bipolaris sorokiniana en Triticum aestivum ".
Además participó en el XXIII Verano de Investigación Científica y Tecnológica del Pacífico en la presentación de su estancia gracias al programa DELFIN y la Universidad de Pamplona.

Parte del trabajo se resumen a continuación:
Evaluación de Bacillus subtilis para contrarrestar la infección provocada por
Bipolaris sorokiniana en Triticum aestivum
Araque Gelves Dayanna Isabel1, De los Santos Villalobos Sergio2
Introducción
El Valle del Yaqui, es la región agrícola más importante para el trigo en México, con una contribución de ~ 40% (1.2 × 106 toneladas) de la producción nacional (www.siap.gob.mx). Villa Rodríguez y col. en 2015 encontraron a B. sorokiniana en plantaciones de trigo con enfermedad foliar en Valle del Yaqui.
B. sorokiniana es un moho que se caracteriza por paredes gruesas, conidios elípticos (con cinco a nueve células. En cultivos axénicos el micelio B. sorokiniana aparece de colores que varan desde blanco hasta negro (Kumar, et al. 2002).
Se ha demostrado que B. sorokiniana causa la enfermedad del tizón foliar en plantas de trigo, dicha enfermedad afecta negativamente los cultivos y por ende el sustento de los agricultores, además de esto este microorganismo afecta también la calidad de las semillas de trigo y su valor en el mercado (Singh, et al. 2018).
Objetivo
Analizar el potencial antimicrobiano de B. subtillis contra B. sorokiana in vitro e in vivo en plantas de trigo.
Conclusiones:
B. subtillis demostró poseer actividad antimicrobiana contra B. sorokiniana, tanto en ensayos in vitro como en vivo, pero su potencial antimicrobiana varía dependiendo de las condiciones ambientales en las que estén expuestos.
Instituto Tecnológico de Sonora ( ITSON), en el Laboratorio de Biotecnología Vegetal

Registro fotografico de los ensayos en la evaluación de Bacillus subtilis para contrarrestar la infección provocada por Bipolaris sorokiniana

B. sorokiniana es un moho que se caracteriza por paredes gruesas, conidios elípticos (con cinco a nueve células. En cultivos axénicos el micelio B. sorokiniana aparece de colores que varan desde blanco hasta negro (Kumar, et al. 2002).